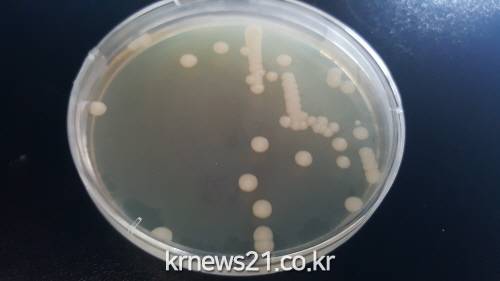

HD현대미포 임직원 및 봉사단체 초롱회, 맛김치 담아 동구지역 취약계층 150세대에 지원
동구종합사회복지관[뉴스21일간=임정훈]HD현대미포(사장 김형관) 임직원 및 대표 봉사단체 초롱회(회장 이경오)는 11월 20일 16시 울산동구종합사회복지관(관장 한영섭)에서 취약계층을 위한 밑반찬 김치나눔사업 ‘마음담아, 행복담아’ 5회차 사업을 진행했다. 이날 겨울철 식생활 부담을 겪는 가정에 실질적인 도움을 주고자 25여명이 ...
경기도농업기술원은 우리 땅에서 찾은 효모를 수제맥주 양조장인 ‘가나다라 브루어리’에 기술이전 한다고 10일 밝혔다.
농기원은 토종 양조 미생물 발굴에 노력한 결과 지난 2016년 향미 성분 생성량이 많고 내산성, 내당성을 갖은 사카로마이세스 세레비지에(Saccharom yces cerevisiae) HY2013을 양조용 효모로 특허 등록했다.
경북 문경에 위치한 ‘가나다라브루어리’는 문경 오미자와 사과로 발효주를 생산하는 업체다. 가나다라브루어리는 최근 수제맥주를 찾는 소비자들이 늘어나고, 향미증진 양조용 토종효모에 대한 관심이 높아지고 있어 농기원의 양조용 효모를 기술이전 받기로 했다.
이번에 기술 이전하는 양조용 효모는 과일 향을 내는 이소아밀알코올 생산 능력이 기존 수입효모에 비해 34% 이상 높아 발효주의 향미를 풍부하게 하는 장점이 있다.
한편, 향미증진 양조용 효모(HY2012와 HY2013)는 지난해 5월 전통주 업체인 술샘(용인), 술아원(여주)과 식초를 생산하는 한희순 발효갤러리(연천)에 기술이전 돼 제품을 생산하고 있다.
김순재 경기도농업기술원장은 “우리 농산물을 우리의 효모로 술을 빚어, 소비자들이 더 사랑하게 될 것으로 기대하고 있다.”며, “경기도에서 개발한 양조효모가 전국적으로 보급되도록 더욱 노력하겠다.”고 말했다.